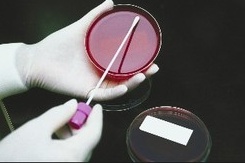

- - 전국 중‧고등학생 대상 결핵관리 중점 추진 -
질병관리본부(본부장: 양병국)는 학교 등 집단시설의 결핵신고가 지속되고 있어, 중·고등학생을 대상으로 결핵환자를 조기에 발견하고 학교 내 전파를 사전에 차단하기 위한 적극적인 계획을 추진할 것이라고 밝혔다.
질병관리본부는 지난 해 중앙결핵역학조사반을 구성(’13.2월)하여 학교에서 전염성 결핵환자가 발생하는 경우, 학생 및 교직원을 대상으로 역학조사와 학부모 설명회 등 교육을 실시하고 있다.
지난해에는 전염성 결핵환자가 신고된 1,200 개 집단시설에 대한 역학조사를 시행하였고, 초·중·고등학교의 경우 총 542명(잠정통계)의 전염성 결핵환자가 신고되어, 해당 426개 전체학교에 대하여 역학조사를 실시하였다.
아울러, 결핵환자 치료지지·관리를 위해 그간 추진하던 민간의료기관 결핵관리전담간호사 지원사업과 더불어 ’14년 지방자치단체에 결핵관리인력 190명을 보강하는 등 선제적 예방 및 치료정책 추진을 위한 기반을 강화한다.
국공립병원·지방의료원 등에 전염성 결핵환자 대상 입원 및 격리치료를 위한 시설을 확충할 계획이며, 스스로 치료 지속이 어려운 결핵환자에 대한 지원을 위해 결핵안심벨트(국립중앙의료원, 국립마산병원, 국립목포병원, 서울특별시립병원)와 협력하여 치료비 지원, 협진, 전원 연계 등을 주요 내용으로 하는 신규 사업을 ’14년 추진하기로 하였다.
질병관리본부는 새 학기가 시작되는 3월부터 전국 중·고등학생과 일반국민을 대상으로 결핵을 바로 알리고, 기침예절 실천문화를 정착시키기 위해 전국 중·고등학교에 가정통신문을 발송하고, TV·라디오 등을 통해 결핵예방 홍보를 집중적으로 추진하기로 했다.
질병관리본부 양병국 본부장은 “우리나라의 부끄러운 건강지표인 결핵발생률을 획기적으로 감소시키기 위해서는 정부의 강력한 정책 추진과 함께 사회적 동참이 중요하다”고 강조하고, 건강한 학업생활을 위해 중·고등학생 스스로가 평소 개인 건강관리를 철저히 하고, 2주 이상 기침이 지속되면 결핵을 의심하고 결핵검사를 받는 것이 중요하다고 덧붙였다.
 울산박물관, 울산 라이징 포트 누적 체험인원 1만 명 돌파…인기몰이 지속
[뉴스21일간=김태인 ] 울산박물관이 지난해 5월부터 운영 중인 가상 도심항공교통(UAM) 체험시설 ‘울산 라이징 포트’가 운영 개시 7개월여 만에 누적 체험 인원 1만 명을 넘어서며 인기몰이를 지속하고 있다. 울산 라이징 포트는 가상 도심항공교통(UAM)을 타고 태화강 국가정원과 반구천의 암각화, 대왕암공원 등 울산의 주요 명소를 실감형 ...
울산박물관, 울산 라이징 포트 누적 체험인원 1만 명 돌파…인기몰이 지속
[뉴스21일간=김태인 ] 울산박물관이 지난해 5월부터 운영 중인 가상 도심항공교통(UAM) 체험시설 ‘울산 라이징 포트’가 운영 개시 7개월여 만에 누적 체험 인원 1만 명을 넘어서며 인기몰이를 지속하고 있다. 울산 라이징 포트는 가상 도심항공교통(UAM)을 타고 태화강 국가정원과 반구천의 암각화, 대왕암공원 등 울산의 주요 명소를 실감형 ...

 북한 장마당, 가내 가공 식료품 활발히 유통
북한 장마당, 가내 가공 식료품 활발히 유통
 김종섭 울산시의회 부의장님과의 인터뷰
김종섭 울산시의회 부의장님과의 인터뷰

 목록으로
목록으로

북한 장마당, 가내 가공 식료품 활발히 유통
북한 장마당, 가내 가공 식료품 활발히 유통
 북한 군용 공항, 겨울철 제설 작업 제한적 현실 확인
북한 군용 공항, 겨울철 제설 작업 제한적 현실 확인
 사리원시 장마당, 소매치기 증가로 주민과 상인 불안 커져
사리원시 장마당, 소매치기 증가로 주민과 상인 불안 커져
 북한, 일반 주민 대상 자동차 소유 확대 방침 발표
북한, 일반 주민 대상 자동차 소유 확대 방침 발표
 러시아 에너지 시설 공습에 키이우 대규모 정전
러시아 에너지 시설 공습에 키이우 대규모 정전










